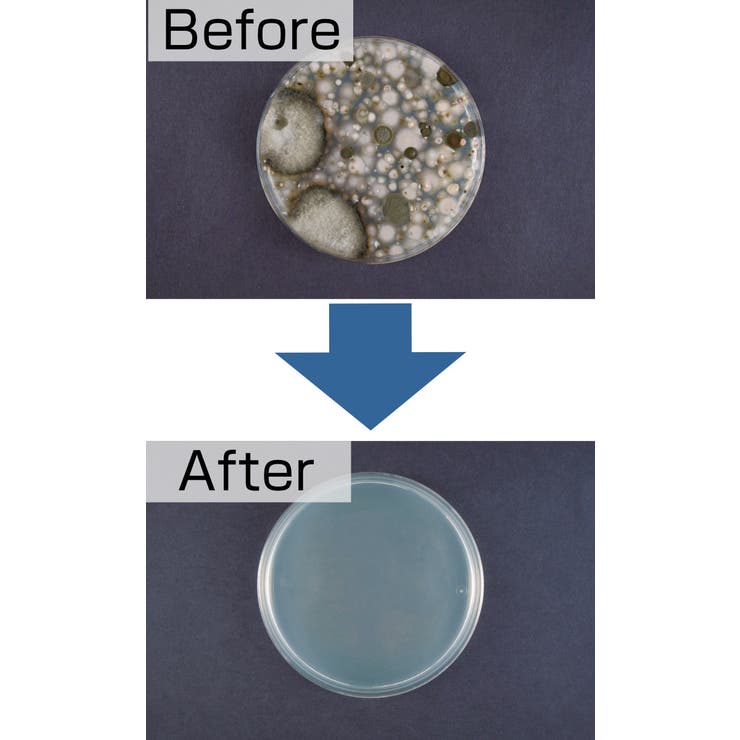
洗濯機掃除 パワーバイオ 洗濯槽のカビきれい | livingut | 詳細画像7

洗濯機掃除 パワーバイオ 洗濯槽のカビきれい
¥1,150 税込
アイテム説明
酸素とバイオのチカラで強力洗浄・消臭・防カビ
●酸素とバイオのチカラで洗濯槽を強力洗浄できる洗濯槽クリーナーです。
●強力洗浄・消臭・防カビの効果があります。
●1包で約45日間洗濯槽のキレイを保ってくれます。
●泡立ちが少ないタイプなので浮き出た汚れも確認しやすいです。
●50g粉末クリーナーが3包入っています。
●酸素とバイオのチカラで洗濯槽を強力洗浄できる洗濯槽クリーナーです。
●強力洗浄・消臭・防カビの効果があります。
●1包で約45日間洗濯槽のキレイを保ってくれます。
●泡立ちが少ないタイプなので浮き出た汚れも確認しやすいです。
●50g粉末クリーナーが3包入っています。
| サイズ | |
| 内容量 | 50g×3包 |
| 材質 | 過炭酸ナトリウム、微生物(バチルス菌属)、酵素 |
| 生産国 | 日本製 |
| ショップ | livingut |
|---|---|
| ショップカテゴリ | livingutの日用品 > livingutのその他日用品 |
| 商品カテゴリ | 日用品 > その他日用品 |
| 品番 | KRFH0024489 |
| ショップ情報 | 本当にもとめていたモノと出会えるトキメキある瞬間、その瞬間を私たちが届けたい。 私たちは「欲しいと出会おう。」をスローガンとし、暮らしを豊かにするモノと出会える、そんな店舗を目指してまいります。 商品にその想いを乗せて、今日もお届けします。 |
このアイテムのお気に入り登録数 1
このブランドのお気に入り登録数 6,970
発送日・お届けまでの日数について
最短本日発送 | ただいまの時間にご注文完了頂くと、最短で本日の発送が可能です。 スピード便発送に関する注意事項はコチラをご確認ください。 |
|---|---|
| ●日~●日後発送予定 | SHOPLIST物流センターに在庫がなく、メーカーから商品を取り寄せる場合。メーカーから商品を取り寄せ後、発送の手続きが開始されます。 |
| ●/●頃発送予定 | 先行・予約販売商品の場合。メーカーから商品を取り寄せ後、発送の手続きが開始されます。 |
| 在庫なし | SHOPLIST物流センターとメーカーで在庫がなく、注文を受け付けられない場合。商品によっては再入荷後、メールでのお知らせが可能です。再入荷リクエストにご登録ください。 |
※発送日・お届けまでの日数についての詳細はコチラをご確認ください。
送料について
通常の送料は一律¥550(税込)となります。
沖縄・各離島も一律¥550(税込)です。
一回のご注文分を全て同梱してお届けいたします。
税抜1,819円以上(税込2,000円以上)購入すると、送料無料になります。
商品のキャンセルについて
ご注文確定後、1時間以内はマイページでキャンセルが可能です。ただし、午前3時~3時59分の間にご注文が確定した場合は、システム更新のため午前4時の時点でキャンセルが不可能となります。
また、キャンセルした注文の請求は、キャリア決済・クレジットカード決済・Paidyでのご注文の場合はキャンセル後に請求があがることはありません。ただし、請求の締め日により、ご注文いただいた月に代金の請求が行われる場合があります。詳細はコチラをご確認ください。
お支払い手段について
代金引換・クレジットカード決済・au PAY(auかんたん決済)・d払い・ソフトバンク・ワイモバイルまとめて支払い・楽天ペイ・Paidyあと払い(3・6・12回払いも可能)・Amazon Pay・メルペイ・PayPayに対応しています。
各種お支払手段についての詳細はコチラをご確認ください。